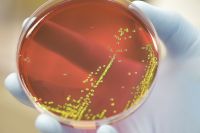
Conheça os principais riscos relacionados à infecção por Salmonella

A Agência Nacional de Vigilância Sanitária (Anvisa) determinou o recolhimento de lote de sardinha congelada após identificar a bactéria Salmonella spp. A regulação foi publicada no Diário Oficial da União nesta terça-feira (29).
De acordo com a agência, estudos laboratoriais detectaram a presença da bactéria em amostras de 25 gramas do “Peixe Congelado Sardinha Laje” (espalmada e eviscerada), da empresa JMS Indústria e Comércio de Pescados, caracterizando assim “resultado microbiológico insatisfatório e condição de impropriedade para consumo humano”.
Leia Mais
-

Por que Anvisa proibiu clobutinol? Substância já é banida de outros países
-

Salmonella: cientistas desenvolvem teste rápido de contaminação de alimentos
-
Conheça os principais riscos relacionados à infecção por Salmonella
Qual o lote atingido?
Segundo a resolução, o recolhimento envolve o lote 13099022444. A Anvisa suspendeu imediatamente a venda e distribuição do produto, ordenando também o recolhimento de todos os lotes disponíveis no mercado.
Essa medida é aplicada quando existe um risco sanitário direto, independentemente de haver registros oficiais de intoxicação vinculados ao lote.
Para aqueles que tiverem adquirido o alimento do respectivo lote, será necessário interromper o consumo imediatamente. É importante buscar o local de compra ou entrar em contato com o fabricante para informações sobre devolução ou descarte correto.
O que é Salmonella
Conforme texto do Ministério da Saúde, a Salmonella é uma bactéria da família das Enterobacteriaceae que causa intoxicação alimentar e em casos raros, pode provocar graves infecções e até mesmo a morte.
A transmissão se dá com a ingestão de alimentos contaminados com fezes de animais. A bactéria é encontrada normalmente em animais como galinhas, porcos, répteis, anfíbios, vacas e até mesmo em animais domésticos, como cachorros e gatos.
Dessa forma, qualquer alimento que venha desses animais ou que tenha entrado em contato com suas fezes podem ser consideradas vias de transmissão da Salmonella.
Os sintomas mais comuns incluem: diarreia, febre, dor abdominal, náuseas e vômitos. Eles podem surgir entre 6 e 72 horas (usualmente entre 12 e 36 horas) após o consumo do alimento contaminado e costumam permanecer por cerca de 2 a 7 dias, até a completa recuperação do paciente.
Maior fábrica de chocolate do mundo interrompe produção após casos de Salmonella
























Comentários: